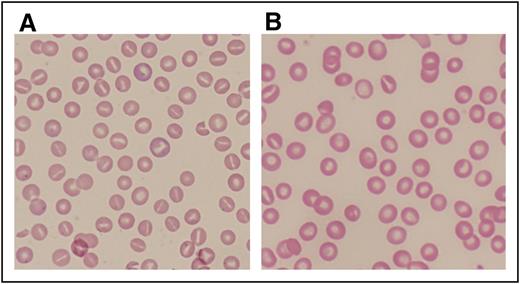
Figure 2. Peripheral blood smears from patients with abnormalities of erythrocyte volume homeostasis. (A) A Wright-stained peripheral blood smear (original magnification ×40) from a patient with hereditary hydrocytosis is shown. Numerous stomatocytes, erythrocytes with a central mouthlike or “stoma” appearance, are seen. (B) A Wright-stained peripheral blood smear (original magnification ×40) from a patient with HX showing rare stomatocytes, dessicytes, which are dense, abnormal erythrocyte forms where hemoglobin appears puddled at the periphery, and target cells.

Abstract
The erythrocyte contains a network of pathways that regulate salt and water content in the face of extracellular and intracellular osmotic perturbations. This allows the erythrocyte to maintain a narrow range of cell hemoglobin concentration, a process critical for normal red blood cell function and survival. Primary disorders that perturb volume homeostasis jeopardize the erythrocyte and may lead to its premature destruction. These disorders are marked by clinical, laboratory, and physiologic heterogeneity. Recent studies have revealed that these disorders are also marked by genetic heterogeneity. They have implicated roles for several proteins, PIEZO1, a mammalian mechanosensory protein; GLUT1, the glucose transporter; SLC4A1, the anion transporter; RhAG, the Rh-associated glycoprotein; KCNN4, the Gardos channel; and ABCB6, an adenosine triphosphate–binding cassette family member, in the maintenance of erythrocyte volume homeostasis. Secondary disorders of erythrocyte hydration include sickle cell disease, thalassemia, hemoglobin CC, and hereditary spherocytosis, where cellular dehydration may be a significant contributor to disease pathology and clinical complications. Understanding the pathways regulating erythrocyte water and solute content may reveal innovative strategies to maintain normal volume in disorders associated with primary or secondary cellular dehydration. These mechanisms will serve as a paradigm for other cells and may reveal new therapeutic targets for disease prevention and treatment beyond the erythrocyte.
Introduction
Maintenance of cellular hydration by regulating water and solute content is critical for survival of the erythrocyte. Several pathways mediate water and solute homeostasis in red blood cells, and their perturbation may jeopardize the integrity of erythrocyte, leading to its premature destruction. Inherited and acquired disorders of erythrocyte hydration are a diverse group of diseases with cellular phenotypes ranging from dehydrated to overhydrated erythrocytes. Heterogeneity in clinical, laboratory, and physiologic manifestations characterizes this group of disorders. Recent studies have revealed that the genetic bases of these disorders are also heterogeneous, with several disease gene loci linked to these disorders.
Erythrocyte hydration
Preservation of cellular hydration is a dynamic process.1 Ion content, hemoglobin concentration, ion transport pathways, membrane surface area, and complex interactions between solutes, their net charge, conductance of the membrane to monovalent anions, and cations all contribute to erythrocyte hydration status.2 Several pathways mediate water and solute homeostasis in erythrocytes, where cellular volume is primarily controlled via regulation of monovalent cation content (Figure 1).1,2
Model of ion transport pathways of the human erythrocyte. Ion transport pathways of the human erythrocyte are shown. Gradient-driven transport pathways include AE1: the anion exchange protein 1, band 3, encoded by SLC4A1; NKCC1 encoding Na-K-Cl cotransporter 1; KCC: K-Cl cotransporters of the family of chloride-cation cotransporters; VDAC: voltage-dependent anion channels; NHE1 encoding the sodium/hydrogen exchanger 1; and VRAC: voltage-regulated anion channels, encoded in part by SWELL1 (LRRC8A). Gradient-driven leak pathways, not otherwise identified and indicated by the arrows, also exist in mature erythrocytes. PIEZO1 is a mechano-activated channel of the erythrocyte membrane. Other erythrocyte membrane channels are the aquaporins, water channels encoded by AQP1 and AQP3, and KCNN4 encoding the Gardos channel, a calcium-activated potassium channel. Active transporters are the calcium ATPase, encoded by ATP2B4, and sodium-potassium ATPase, the multicomponent sodium pump composed of α1 and α3 isoforms, β1, β2, and β3 isoforms, and the γ modulator. NMDAR, the multicomponent N-methyl d-aspartate receptor participating in calcium regulation in erythroid cells, is also shown. Other transport pathways (eg, CO2, amino acids, glucose, urea, etc) are not shown.
Model of ion transport pathways of the human erythrocyte. Ion transport pathways of the human erythrocyte are shown. Gradient-driven transport pathways include AE1: the anion exchange protein 1, band 3, encoded by SLC4A1; NKCC1 encoding Na-K-Cl cotransporter 1; KCC: K-Cl cotransporters of the family of chloride-cation cotransporters; VDAC: voltage-dependent anion channels; NHE1 encoding the sodium/hydrogen exchanger 1; and VRAC: voltage-regulated anion channels, encoded in part by SWELL1 (LRRC8A). Gradient-driven leak pathways, not otherwise identified and indicated by the arrows, also exist in mature erythrocytes. PIEZO1 is a mechano-activated channel of the erythrocyte membrane. Other erythrocyte membrane channels are the aquaporins, water channels encoded by AQP1 and AQP3, and KCNN4 encoding the Gardos channel, a calcium-activated potassium channel. Active transporters are the calcium ATPase, encoded by ATP2B4, and sodium-potassium ATPase, the multicomponent sodium pump composed of α1 and α3 isoforms, β1, β2, and β3 isoforms, and the γ modulator. NMDAR, the multicomponent N-methyl d-aspartate receptor participating in calcium regulation in erythroid cells, is also shown. Other transport pathways (eg, CO2, amino acids, glucose, urea, etc) are not shown.
Potassium concentration in the erythrocyte is high, ∼140 mEq/dL, compared with 4 to 5 mEq/dL in the plasma, whereas sodium concentration is low, ∼10 mEq/dL, compared with ∼140 mEq/dL in the plasma. These concentration gradients lead to passive movement of sodium into and potassium out of the erythrocyte. The low-sodium, high-potassium internal environment of the erythrocyte is maintained by the Na+K+ pump (Na+K+ATPase), which actively transports sodium out of and potassium into the cell in a 3:2 stoichiometry, thereby equaling the normal passive movement of these cations into and out of the cell, respectively.3
At steady state, erythrocyte membrane ion permeability is very low, preventing osmotic-driven alterations in cell volume. Passive cation electrodiffusion (leak) permits outward potassium and inward sodium gradients. However, the cell has limited capacity to respond to alterations in monovalent cation content, and, if exceeded, cellular volume will change in parallel with the change in the total content of cations. When sodium diffusion inward exceeds potassium diffusion out, erythrocytes swell. When outward potassium diffusion exceeds sodium diffusion in, erythrocytes shrink. Changes in these pathways and in membrane permeability are detected by the measurement of intracellular sodium, potassium, and total cation content as well as altered indices of erythrocyte hydration (eg, increased or decreased mean corpuscular hemoglobin concentration [MCHC]).2,4
The average cell volume of reticulocytes normally decreases from 115 fL after release from the bone marrow to 85 fL after remodeling into a mature erythrocyte. In parallel, cell hemoglobin concentration (CHC) increases from ∼27 to ∼33 g/dL. Cell volume and CHC remain remarkably stable over most of the normal erythrocyte lifespan.
Disorders of erythrocyte hydration
Disorders of erythrocyte hydration are classified as primary, due to inherent disorders of erythrocyte volume regulation, and secondary, due to other disorders affecting the erythrocyte that secondarily influence cell hydration. In general, the degree of perturbation of water and ion content parallels the degree of hemolytic anemia.
Primary disorders of erythrocyte hydration
Overhydration
Primary disorders are classified by the perturbation of intracellular water content (ie, overhydration or dehydration), which reflects the abnormality in membrane permeability to sodium and potassium. Another classification system utilizes temperature dependence of the cation leak observed.4 Initially, these were called hereditary stomatocytosis syndromes because of the variable numbers of stomatocytes observed on peripheral blood smear from affected patients. However, stomatocytes are observed in several other inherited and acquired erythrocyte disorders and are observed rarely or not at all in some hydration disorders.
Overhydrated stomatocytosis (or hereditary hydrocytosis)
Overhydrated stomatocytosis (OHSt) or hereditary hydrocytosis refers to a rare, heterogeneous group of disorders with hemolytic anemia and large numbers of stomatocytes on peripheral blood smear (Table 1). OHSt is associated with markedly increased sodium permeability of the membrane,5 anywhere from 10 to 40 times normal. This leads to a significant increase in intracellular sodium with a lesser decrease in intracellular potassium, resulting in increased total monovalent cation content and increased intracellular water. There is a significant compensatory increase in Na+K+ATPase activity, but this increase does not fully compensate for the increased sodium content and cells swell. Erythrocyte membranes from many OHSt patients lack stomatin, but mutations have not been found in the gene of affected patients and erythrocytes from stomatin knockout mice are normal.5
Features of primary disorders of erythrocyte volume homeostasis
| . | Overhydration syndromes . | Intermediate syndromes . | Dehydration syndromes . | ||||
|---|---|---|---|---|---|---|---|
| Condition . | Overhydrated hereditary stomatocytosis (hydrocytosis) . | Mild hereditary stomatocytosis . | Cryohydrocytosis . | Stomatocytic xerocytosis . | Xerocytosis with high phosphatidyl-choline . | Xerocytosis . | FP . |
| Hemolysis | Severe | Mild to moderate | Mild to moderate | Mild | Mild to moderate | Moderate | None |
| Anemia | Severe | Mild to moderate | Mild to moderate to compensated | None | Moderate | Mild to moderate | None |
| Blood smear | Stomatocytes ± spherocytes | Stomatocytes and/or spherocytes | Stomatocytes ± spherocytes ± targets | Stomatocytes | Targets, echinocytes | Targets, rare stomatocytes, or dessicytes | Rare target or stomatocyte |
| MCV (80-100 fL)* | 110-150 | 95-130 | 90-105 | 91-98 | 100-110 | 90-110 | 82-104 |
| MCHC (32-36g/dL) | 24-30 | 26-30 | 34-40 | 33-39 | 34-38 | 34-38 | 33-39 |
| Unincubated osmotic fragility | Very increased | Increased | Variable | Decreased | Very decreased | Decreased to very decreased | Slightly decreased |
| RBC Na+ (5-12 mEq/LRBC) | 60-150 | 30-60 | 15-100 | 10-20 | 10-20 | 5-30 | 10-25 |
| RBC K+ (90-103 mEq/LRBC) | 20-55 | 40-85 | 30-100 | 75-85 | 60-80 | 60-100 | 75-110 |
| RBC Na+ + K+ (95-110 mEq/LRBC) | 110-170 | 115-145 | 70-130 | 87-103 | 75-90 | 70-110 | 85-110 |
| Phosphatidyl-choline content | Normal | ± Increased | Normal | Normal | Increased | Normal or increased | Normal |
| Cold autohemolysis | No | Unknown | Yes | No | Unknown | No | No |
| Pseudohyperkalemia | Sometimes | Unknown | Yes | Sometimes | Sometimes | Sometimes | Yes |
| Effect of splenectomy† | Good | Good | Little or no effect | Unknown | Unknown | Poor | Not applicable |
| Thromboembolism risk postsplenectomy | Yes | Unknown | ? Yes | Unknown | Unknown | Yes | Unknown |
| Inheritance | Autosomal dominant | Autosomal dominant | Autosomal dominant | Autosomal dominant | Autosomal dominant | Autosomal dominant, de novo | Autosomal dominant |
| Gene defects | RHAG | SLC4A1 | SLC4A1, GLUT1 | PIEZO1, unknown | PIEZO1, unknown | PIEZO1, KCNN4 | ABCB6, PIEZO1 |
| . | Overhydration syndromes . | Intermediate syndromes . | Dehydration syndromes . | ||||
|---|---|---|---|---|---|---|---|
| Condition . | Overhydrated hereditary stomatocytosis (hydrocytosis) . | Mild hereditary stomatocytosis . | Cryohydrocytosis . | Stomatocytic xerocytosis . | Xerocytosis with high phosphatidyl-choline . | Xerocytosis . | FP . |
| Hemolysis | Severe | Mild to moderate | Mild to moderate | Mild | Mild to moderate | Moderate | None |
| Anemia | Severe | Mild to moderate | Mild to moderate to compensated | None | Moderate | Mild to moderate | None |
| Blood smear | Stomatocytes ± spherocytes | Stomatocytes and/or spherocytes | Stomatocytes ± spherocytes ± targets | Stomatocytes | Targets, echinocytes | Targets, rare stomatocytes, or dessicytes | Rare target or stomatocyte |
| MCV (80-100 fL)* | 110-150 | 95-130 | 90-105 | 91-98 | 100-110 | 90-110 | 82-104 |
| MCHC (32-36g/dL) | 24-30 | 26-30 | 34-40 | 33-39 | 34-38 | 34-38 | 33-39 |
| Unincubated osmotic fragility | Very increased | Increased | Variable | Decreased | Very decreased | Decreased to very decreased | Slightly decreased |
| RBC Na+ (5-12 mEq/LRBC) | 60-150 | 30-60 | 15-100 | 10-20 | 10-20 | 5-30 | 10-25 |
| RBC K+ (90-103 mEq/LRBC) | 20-55 | 40-85 | 30-100 | 75-85 | 60-80 | 60-100 | 75-110 |
| RBC Na+ + K+ (95-110 mEq/LRBC) | 110-170 | 115-145 | 70-130 | 87-103 | 75-90 | 70-110 | 85-110 |
| Phosphatidyl-choline content | Normal | ± Increased | Normal | Normal | Increased | Normal or increased | Normal |
| Cold autohemolysis | No | Unknown | Yes | No | Unknown | No | No |
| Pseudohyperkalemia | Sometimes | Unknown | Yes | Sometimes | Sometimes | Sometimes | Yes |
| Effect of splenectomy† | Good | Good | Little or no effect | Unknown | Unknown | Poor | Not applicable |
| Thromboembolism risk postsplenectomy | Yes | Unknown | ? Yes | Unknown | Unknown | Yes | Unknown |
| Inheritance | Autosomal dominant | Autosomal dominant | Autosomal dominant | Autosomal dominant | Autosomal dominant | Autosomal dominant, de novo | Autosomal dominant |
| Gene defects | RHAG | SLC4A1 | SLC4A1, GLUT1 | PIEZO1, unknown | PIEZO1, unknown | PIEZO1, KCNN4 | ABCB6, PIEZO1 |
Modified in part from Lux122 with permission.
K+, potassium; LRBC, liter of red blood cells; MCV, mean corpuscular volume; Na+, sodium; PC, phosphatidylcholine; RBC, red blood cell.
Values in parentheses are the normal range.
Splenectomy is contraindicated in these disorders.
OHSt patients exhibit moderate to severe, partially compensated hemolytic anemia (Table 1). A few patients experience less severe hemolytic anemia. The large increase in intracellular sodium and water leads to large, macrocytic erythrocytes (100 to 150 fL) (Figure 2A) that are osmotically fragile (Figure 3) with a low MCHC (24 to 30 g/dL) and a rightward shift of the ektacytometry curve. Although hemolytic anemia is improved after splenectomy, most consider splenectomy contraindicated because of the high risk of postsplenectomy thromboembolic disease and chronic pulmonary hypertension.6 Erythrocytes from splenectomized OHSt patients demonstrate increased phosphatidylserine exposure and increased erythrocyte-endothelial cell adhesion.7 There is no specific therapy for OHSt, and treatment is supportive.
Peripheral blood smears from patients with abnormalities of erythrocyte volume homeostasis. (A) A Wright-stained peripheral blood smear (original magnification ×40) from a patient with hereditary hydrocytosis is shown. Numerous stomatocytes, erythrocytes with a central mouthlike or “stoma” appearance, are seen. (B) A Wright-stained peripheral blood smear (original magnification ×40) from a patient with HX showing rare stomatocytes, dessicytes, which are dense, abnormal erythrocyte forms where hemoglobin appears puddled at the periphery, and target cells.
Peripheral blood smears from patients with abnormalities of erythrocyte volume homeostasis. (A) A Wright-stained peripheral blood smear (original magnification ×40) from a patient with hereditary hydrocytosis is shown. Numerous stomatocytes, erythrocytes with a central mouthlike or “stoma” appearance, are seen. (B) A Wright-stained peripheral blood smear (original magnification ×40) from a patient with HX showing rare stomatocytes, dessicytes, which are dense, abnormal erythrocyte forms where hemoglobin appears puddled at the periphery, and target cells.
Laboratory analyses of erythrocyte hydration. (A) Incubated osmotic fragility. Osmotic fragility curves in OHSt and HX. The shaded region is the normal range. Diagrammatic representation of both OHSt (blue) and HX (red) curves is shown. (B) Osmotic gradient ektacytometry. Characteristics of erythrocyte dehydration in HX include mildly reduced deformability index with a leftward shift of the minimal osmolality point (Omin, the osmolality yielding release of 50% of hemoglobin reflecting the surface area to volume ratio of erythrocytes) and a leftward shift of the maximal osmolality point (which contains Ohyper or O′). In OHSt, the deformability index is normal or nearly normal and the minimal and maximal osmolality points are shifted to the right.
Laboratory analyses of erythrocyte hydration. (A) Incubated osmotic fragility. Osmotic fragility curves in OHSt and HX. The shaded region is the normal range. Diagrammatic representation of both OHSt (blue) and HX (red) curves is shown. (B) Osmotic gradient ektacytometry. Characteristics of erythrocyte dehydration in HX include mildly reduced deformability index with a leftward shift of the minimal osmolality point (Omin, the osmolality yielding release of 50% of hemoglobin reflecting the surface area to volume ratio of erythrocytes) and a leftward shift of the maximal osmolality point (which contains Ohyper or O′). In OHSt, the deformability index is normal or nearly normal and the minimal and maximal osmolality points are shifted to the right.
Erythrocytes from a subset of OHSt patients demonstrate substantial cation leak at physiologic temperature as well as absence of stomatin. These patients have heterozygous missense mutations in the second predicted transmembrane domain of RhAG, the Rh-associated glycoprotein.8 RhAG, along with RHCE, RHD, CD47, LW, glycophorin B, and other proteins, is a component of the band 3 protein macromolecular complex. In this complex, RhAG may function as an ammonium transporter or a gas channel.9,10 Studies suggest OHSt-associated RhAG mutations may widen the transport channel, allowing passage of cations through this channel or through new permeability pathways.5,9,11
Cryohydrocytosis
Cryohydrocytosis is an OHSt variant in which patient erythrocytes exhibit minimal to mild changes in cation leak at physiologic temperatures, but a marked increase in monovalent cation permeability at low temperature, typically 5°C (Table 1). Erythrocytes demonstrate a spherostomatocytic morphology on peripheral smear. Heterozygous missense mutations in band 3, the anion exchanger (SLC4A1), have been identified in some cryohydrocytosis patients.12-16 Mutations in this region inactivate band 3–mediated anion exchange in vitro.5 These mutations, which are expressed in the membrane of mutant cells, may induce an abnormal cation leak,12,17 or the mutant band 3 may activate other endogenous cation leak pathways.14,18
The cold-induced cation leak in erythrocytes from patients with Southeast Asian ovalocytosis, a rare disorder associated with an in-frame 9-amino-acid deletion in band 3 located a distance from the anion translocation region, is indistinguishable from that observed in cryohydrocytosis.19
Variants of cryohydrocytosis have been described in rare patients with abnormalities of GLUT1, the glucose transporter.20 Erythrocytes with echinocytic morphology and a cation leak were first reported in a patient with paroxysmal exertion-induced dyskinesia, a mild variant of GLUT1 deficiency.21 Subsequently, other GLUT1-deficient patients were described with hemolytic anemia the erythrocytes of which exhibited a low-temperature cation leak similar to cryohydrocytosis, and stomatin deficiency similar to OHSt.22,23 Stomatin interacts with and influences GLUT1 activity, switching its preferred substrate from glucose to dehydroascorbic acid, an oxidized form of vitamin C.24 These observations led to the hypothesis that by reducing membrane stomatin, cryohydrocytosis erythrocytes can maximize their glucose uptake to meet the increased demands of the metabolically stressed cell.8 Some OHSt and variant patients do not have mutations in the RHAG, SLC4A1, or GLUT1 genes.
Dehydration
After shrinkage due to dehydration, most mammalian cell types respond with a process known as regulatory volume increase (RVI), first described in nonmammalian erythrocytes,25 which is mediated primarily by Na+/H+ exchange, Na+-K+-2Cl− cotransport, and Na+ channels.1 Human erythrocytes are among a very few cell types that do not respond to solute loss with RVI.26 Thus, decreased volume caused by solute loss is essentially an irreversible process in erythrocytes, and as they age, red blood cells lose volume and become denser.27 This lack of RVI is a critical component of the pathophysiology of dehydration in sickle cell disease (SCD).28 The contribution of aquaporins and SWELL1, a recently identified component of the volume-regulated anion channel, to erythrocyte volume regulation is unknown.29,30
Hereditary xerocytosis (dessiscytosis, dehydrated stomatocytosis)
The hereditary xerocytosis (HX) syndromes are the most common primary disorder of erythrocyte hydration and are the most clinically heterogeneous (Table 1).31 HX erythrocytes are dehydrated due to a cation leak, primarily of potassium, that leads to decreased potassium concentration. Because the cation leak is not accompanied by a proportional net gain of sodium and water, cellular dehydration ensues.32
Inheritance is autosomal dominant with de novo cases reported.31,33 Anemia is variable, with typical patients suffering from mild to moderate, compensated hemolytic anemia. Some patients do not come to medical attention until late in life. HX erythrocytes may be paradoxically normocytic and macrocytic despite cell dehydration resulting in loss of water and resultant decreases in cell volume and increased CHC. Reticulocytosis may contribute to the elevated MCV.
Peripheral blood smear reveals a few target cells, occasional dessicytes-erythrocytes with hemoglobin puddled to 1 side, and rare stomatocytes (Figure 2B).34 MCHC is increased (34-38 g/dL), and erythrocyte osmotic fragility is decreased, both reflecting cellular dehydration (Figure 3A).35 Osmotic gradient ektacytometry shows a characteristic pattern, a reduced deformability index with a leftward shift of the minimal osmolality point (Figure 3B), also reflecting cellular dehydration.
Hemolysis-related complications include hemolytic and aplastic crises, thromboses, and gallstones. In addition to the abnormalities related to hemolysis, some patients suffer from transient perinatal edema and nonimmune hydrops fetalis of unknown cause that spontaneously resolves, and/or suffer from pseudohyperkalemia.36 Iron overload, independent of transfusion history, may be significant in adult HX patients, to the point of requiring chelation therapy.37,38 The cause of iron overload is unknown. Serial determinations of iron indices are suggested.
Treatment of HX patients is supportive. Splenectomy is contraindicated due to development of postsplenectomy thromboses in HX patients, like OHSt. The Gardos channel blocker Senicapoc may be of benefit.39-41
PIEZO1.
Mutations in PIEZO1 have been identified in most cases of HX studied at the genetic level.42-44 PIEZO proteins have been identified as ion channels mediating mechanosensory transduction in mammalian cells.45 PIEZO1 is a large integral membrane protein with numerous transmembrane domains that assemble into a homo-multimeric complex fully active as a mechanosensitive cation channel (Figure 4A).46-50 Most HX-associated PIEZO1 mutations are missense mutations in the highly conserved COOH-terminal region associated with the pore. Three mutations, R2456H, T2127M, and E2496ELE, have been identified in >50% of HX cases. Many HX-associated PIEZO1 mutations exhibit a partial gain-of-function phenotype, with generation of mechanically activated channels that inactivate more slowly than wild type in cell model systems (Figure 4B).42,43,51 This suggests that increased cation permeability may lead to dehydration of PIEZO1-HX erythrocytes. Recent studies indicate other mechanisms, including alterations in mutant PIEZO1 channel kinetics, differences in response to osmotic stress, and altered membrane protein trafficking, may worsen or ameliorate erythrocyte hydration in HX.33
PIEZO1. (A) Proposed model of PIEZO channels based on cryoelectron microscopy imaging.49 Gray and tan models represent closed and open channels. Red dashed lines indicate possible ion-conduction pathways. Presumably, force-induced motion (arrows) of the peripheral blade or peripheral helices (PH) leads to conformational arrangement and gating of the channel. Reprinted from Ge et al49 with permission. (B) Human PIEZO1 channels with HX-associated mutations display slow inactivation kinetics. HEK293 cells expressing mutant PIEZO1 were stimulated by a series of mechanical steps. Representative traces of mechanically activated inward currents from cells expressing wild-type (WT; red) or mutant (blue) PIEZO1 normalized to peak. Maximum currents from each mutant are overlaid to highlight differences in inactivation kinetics.43 CED, extracellular COOH-terminal domain; CTD, intracellular COOH-terminal domain; IH, inner helix; OH, outer helix.
PIEZO1. (A) Proposed model of PIEZO channels based on cryoelectron microscopy imaging.49 Gray and tan models represent closed and open channels. Red dashed lines indicate possible ion-conduction pathways. Presumably, force-induced motion (arrows) of the peripheral blade or peripheral helices (PH) leads to conformational arrangement and gating of the channel. Reprinted from Ge et al49 with permission. (B) Human PIEZO1 channels with HX-associated mutations display slow inactivation kinetics. HEK293 cells expressing mutant PIEZO1 were stimulated by a series of mechanical steps. Representative traces of mechanically activated inward currents from cells expressing wild-type (WT; red) or mutant (blue) PIEZO1 normalized to peak. Maximum currents from each mutant are overlaid to highlight differences in inactivation kinetics.43 CED, extracellular COOH-terminal domain; CTD, intracellular COOH-terminal domain; IH, inner helix; OH, outer helix.
What is the role of PIEZO1 in erythroid cells? Does it regulate a stretch-activated calcium pathway?52 Upon deformation, calcium enters the erythrocyte through an as yet unidentified pathway.53,54 Local deformations in the erythrocyte membrane transiently activate a calcium-permeability pathway leading to increased intracellular calcium, with activation of potassium currents through the calcium-sensitive Gardos channel and secondary anion currents through other channels.55 Circulatory shear stress has been suggested to cause reversible increases in erythrocyte calcium permeability.54,56 Erythrocyte aging has been associated with alterations in membrane permeability for calcium.57 Localized membrane deformation has been associated with increased calcium in the initial steps of malaria invasion,58 a process recently linked to PIEZO1 phosphorylation.59
It has been suggested that PIEZO plays a role in erythrocyte volume regulation,60 with PIEZO1-mutant HX erythrocytes gradually becoming dehydrated during their repeated cycles of travel through the microcirculation, associated with changes in oxygenation/deoxygenation.61 Volume sensing, a poorly understood process in vertebrate cells, has been linked to stretch-activated currents induced by changes in cell volume.62 The PIEZO1 blocker, Grammostola spatulata mechanotoxin, inhibits mechanically activated currents and whole cell regulatory volume decreases, indicating a role in volume homeostasis.63 PIEZO1 also regulates the mechanotransductive release of adenosine triphosphate (ATP) from human erythrocytes.64 Mice with Piezo1 deletion in hematopoietic and endothelial cells demonstrate erythrocyte macrocytosis and an overhydrated phenotype, but complex erythrocyte-endothelial cell interactions mandate cautious interpretation of these results due to the critical role of PIEZO1 in endothelial cells.60
PIEZO1 mutations have also been identified in patients with autosomal recessive congenital lymphatic disorders with a high incidence of nonimmune hydrops fetalis without HX,65,66 suggesting PIEZO1 plays a role in lymphatic development. These findings are interesting considering the variable occurrence of nonimmune hydrops fetalis in HX patients, independent of fetal anemia.42,67,68
The Gardos channel.
A few HX patients do not have mutations in PIEZO1, but instead have mutations in the Gardos channel, encoded by KCNN4.69-72 Important in the dehydration pathways active in sickle erythrocytes (see below), a role for the Gardos channel in normal erythrocytes has not been defined. HX-associated mutant KCNN4 channels demonstrate alterations in channel kinetics and trafficking. Clinically, HX patients with KCNN4 mutations experience variable degrees of anemia and erythrocyte dehydration with typically more severe anemia than PIEZO1-mutant HX patients. Affected individuals in 1 KCNN4-associated HX kindred experienced chronic hemolytic anemia but minimal to no erythrocyte dehydration.72 Associated findings, including nonimmune hydrops fetalis and pseudohyperkalemia, have not been observed, and nontransfusion-associated iron overload appears to be less severe and more variable.
Intermediate syndromes
OHSt and HX represent the extremes of a spectrum of red cell permeability defects (Table 1).31 Kindreds with features of both conditions have been reported. Some patients with severe permeability defects exhibit little or no hemolysis. Others have increased phosphatidylcholine in their erythrocyte membranes.73,74
Familial pseudohyperkalemia
Familial pseudohyperkalemia (FP) is a dominantly inherited disorder not associated with hemolytic anemia characterized by increased serum potassium in blood stored for prolonged periods at or below room temperature (Table 1).37,75,76 Elevated potassium is due to a mild cation leak after cooling that is insignificant at room temperature.5 FP patients are otherwise clinically well.77,78 FP patients have heterozygous mutations in ABCB6,77 a mitochondrial porphyrin transporter also present in the erythrocyte membrane, where it carries the Lan (Langereis) blood group antigen.79,80 ABCB6 is also found in exosomes released from reticulocytes during the final steps of terminal erythropoiesis.81 The prevalence of FP in the general population is unknown. When present in blood donors, the marked potassium leak after storage could be of concern, particularly in countries where whole blood may be transfused in large volumes to critically ill infants.82,83
FP-associated mutations are thought to act as gain-of-function variants, inducing a cation leak through the normal substrate translocation pathway of ABCB6, by generating a novel constitutive or cyclic leak pathway, or by activating alternate cation permeability pathways. Individuals with Lan-negative erythrocytes have recessive, null mutations in ABCB6 without leaky erythrocytes or any other clinical manifestations. Pseudohyperkalemia has also been observed in patients with PIEZO1-associated HX and GLUT1 deficiency (Table 1).
Secondary disorders of erythrocyte hydration
Dehydration is a secondary effect of several erythrocyte disorders, including SCD, thalassemia, hemoglobin C, hereditary spherocytosis (HS), and malaria invasion. In these disorders, secondary perturbation of erythrocyte water content may be a major contributor to disease pathophysiology.
SCD
Erythrocyte dehydration is a critical contributor to disease pathogenesis in SCD. Because sickle hemoglobin polymerization in deoxygenated conditions is exquisitely dependent on its cellular concentration, increased CHC resulting from dehydration significantly increases the tendency of erythrocytes to sickle, reducing the delay time for polymerization of deoxygenated sickle hemoglobin, and leading to persistence of the polymer in the oxygenated state.84 Dilution of deoxyhemoglobin S by water or a nonsickling hemoglobin, such as fetal hemoglobin, increases delay time and polymer formation enough to allow sickle erythrocytes to arrive into the venous system or even to travel back to the lungs before polymerization has occurred. A number of reviews have excellent detailed discussion of the concepts summarized below.2,26,28,85-87
Hemoglobin concentration of normal erythrocytes is tightly regulated in a narrow range, whereas in circulating sickle erythrocytes, hemoglobin concentration varies widely. Much of this variability is directly correlated with cellular hydration state, including populations of dehydrated erythrocytes known as dense cells. The hemoglobin concentration of the densest sickle erythrocytes may reach 50 g/dL, with up to 40% of sickle erythrocytes exhibiting concentrations of ≥38 g/dL, a value found in <1% of normal erythrocytes. Enriched in irreversibly sickled cells, dense cells exhibit decreased deformability, increased fragility, and increased adhesion to endothelial cells, leukocytes, and other sickle erythrocytes, that exacerbates endothelial damage and facilitates vaso-occlusion. Percentages of circulating dense cells vary between patients and over time in the same patient, ranging from 0% to 40%. Dense sickle erythrocytes are more susceptible to hemolysis, and numbers of circulating dense cells have been positively correlated with severity of hemolysis in SCD.88 Hemolysis and the hemolytic rate contribute to significant complications of SCD, including pulmonary hypertension, stroke, priapism, and leg ulcers.89
In SCD, complex interactions between the polymerization of hemoglobin S (HbS) and activity of several water and solute transport systems lead to cellular dehydration. At least 3 pathways mediate cation loss and cellular dehydration of sickle erythrocytes, a potassium chloride cotransport (KCC) pathway, a sickling-induced, deoxy-dependent nonselective cation leak pathway called Psickle that mediates an increase in permeability to calcium and other ions at the initiation of the dehydration cascade, and a calcium-activated potassium channel, the Gardos channel, which when activated is the primary mediator of potassium and water loss in SCD.
KCC.
KCC is the primary volume-sensitive cation transport pathway in erythrocytes. Activation of KCC leads to cellular loss of potassium, chloride, and water, decreasing erythrocyte volume and increasing cellular hemoglobin concentration. The activity of KCC pathways, which normally control the reduction in cell volume during reticulocyte maturation, progressively decreases to near negligible levels in aged, mature erythrocytes.90,91
KCC activity in sickle erythrocytes is dysregulated, with pathologically elevated activity leading to increased CHC after activation, priming the erythrocyte to sickle. Dysregulation of KCC in SCD is complex, varying quantitatively and temporally in SCD patients.91 Its cause(s) is unknown, with numerous contributing etiologies postulated, including abnormal redox state, erythrocyte magnesium depletion, and combinations of environmental and genetic factors. Although numerous in vitro activators of KCC activity have been described, including cell swelling, acid pH, urea, and decreased cellular magnesium, the specific relative contributions of activators in vivo are less clear. These observations have led to trials of antioxidants and magnesium replacement therapy in attempts to regulate KCC activity in sickle erythrocytes.
KCC activity is mediated by members of the SLC12 family of electroneutral cation-coupled chloride cotransporters. In human erythrocytes, there are 3 KCCs: KCC1, KCC3, and KCC4.92 The contribution of each of these transporters to KCC activity in erythrocytes is unknown. These transporters may interact, influencing KCC activity. Differences in these interactions, isoform composition determined by alternate splicing, posttranslational modifications, and other differences have been hypothesized as potential contributors to differences in normal and sickle erythrocytes.93
The Gardos channel.
The Gardos channel is a calcium-sensitive, intermediate-/small-conductance, potassium channel. Initially described as a regulator of calcium-activated potassium efflux from ATP-depleted erythrocytes, it has subsequently been found in many cell and tissue types where it plays diverse roles in normal and pathologic processes such as immune function, vascular biology, neuroprotection, and asthma.94 In normal, mature erythrocytes, the function of the Gardos channel is unknown. The Gardos channel is normally inactive, yet when fully activated, it has the capacity to trigger rapid erythrocyte dehydration, far beyond the capacity of other erythrocyte channels or transporters. The Gardos channel has been shown to participate in pathologic states affecting the erythrocyte, such as complement-mediated hemolysis, HS, and SCD.2,95,96
In SCD, the Gardos channel is the major pathway mediating dehydration in sickle erythrocytes after its activation by calcium. Several mechanisms may lead to increases in intracellular red cell calcium: activation of the deoxygenation-induced Psickle pathway, modulation of calcium channels by cytokines or inflammatory mediators, or activation of stretch-induced cation channels by circulatory shear stress. Because of its importance, strategies to block Gardos channel activity in SCD have been pursued (see below).97
Psickle.
Psickle is a deoxy-dependent nonselective ion and small solute permeability pathway that mediates reversible increases in permeability to calcium and other cations in sickle erythrocytes, at the initiation of the dehydration cascade.85,98 Although it acts as a direct pathway for potassium loss that is mostly balanced by sodium entry, its primary effect is the promotion of calcium entry into the erythrocyte, leading to Gardos channel activation, a critical step in the dehydration of sickle erythrocytes.97,99 Psickle also stimulates magnesium loss, which then facilitates loss of potassium and chloride via increased activity of KCC.26,100
The molecular nature of Psickle is unknown. It is defined as a nonselective cation conductance pathway active under conditions of deoxygenation, HbS polymerization, and red cell shape change/shear stress, that is somehow activated or generated by interaction of deoxygenated HbS polymers with components of the erythrocyte membrane.101 Numerous candidates have been suggested for the Psickle pathway, which could be composed of numerous components. Band 3 was once suggested because the anion transporter inhibitor 4,4-diisothiocyano-2,2′disulfostilbene inhibited deoxygenation-induced cation fluxes in sickle cells.99,102 N-methyl d-aspartate receptors have been candidates because of the many shared properties with Psickle.103 More recently, PIEZO1 has been suggested as a candidate, because membrane deformation is necessary for the increase in sickling-induced cation permeability mediated by Psickle, and there are strong similarities between erythrocyte nonspecific cation conductance pathways and Psickle, including sensitivity to Grammostola spatulata mechanotoxin, indicating Psickle has properties of a mechanosensitive ion channel.104,105 Because studies have shown Psickle is a completely reversible permeability pathway,106 if it could be identified, it would be a very attractive candidate for therapeutic targeting.107
Hemoglobin SC disease
Hemoglobin SC is the second most common type of SCD. SC patients, who suffer the same complications as SS patients, but particularly painful crises, retinopathy, avascular necrosis, and hearing disorders, typically have less severe disease and longer lifespans.108 The fact that SC individuals with 40% to 50% HbS in their erythrocytes have any symptoms at all is a paradox, compared with AS individuals with 30% to 40% HbS in their erythrocytes who are largely asymptomatic. The pathophysiology of SC disease has been attributed to erythrocyte dehydration, which raises levels of intracellular HbS to critical levels. SC erythrocytes leak cations and water linked to overactivity of KCC,109 and KCC activity in SC erythrocytes has been correlated with disease severity.110 Differences in the pathophysiology of SS and SC disease have led to calls for consideration for SC-specific management protocols.108
Targeting hydration pathways in SCD
Prevention of erythrocyte dehydration by modifying intracellular water and solute content has been an appealing therapeutic strategy because sickle hemoglobin polymerization is a concentration-dependent process.84 Studies manipulating total body water of SCD patients by providing large amounts of hypotonic fluids and treatment with antidiuretic hormone provided proof of principle in decreased vaso-occlusive crises, but were impractical and had side effects.111 Trials have targeted pathways leading to potassium loss and cellular dehydration, including use of dipyridamole, an inhibitor of the deoxygenation-induced cation leak, magnesium supplementation to influence KCC activity, and blockade of the Gardos channel with imidazole antimycotics, including Senicapoc, or arginine. In the Senicapoc trial, numbers of dense cells and hemolytic anemia were improved in treated patients,112 yet there was no significant improvement in the rate of painful crises and the study was ended early.
The results of most of these therapeutic studies have been disappointing, with clinical responses ranging from none to variable to incomplete. To develop effective therapeutics targeting erythrocyte hydration, a more complete understanding of the pathways regulating volume homeostasis is required. Also, because there was variability between patient responses in these previous studies, a better understanding of the genetic factors influencing erythrocyte hydration are needed. Ultimately, pharmacogenomic signatures could be used to predict which patients will or will not benefit from hydration-altering treatment strategies.
Hereditary Spherocytosis
The membrane defect in HS leads to a variety of secondary metabolic changes. These include increased sodium and potassium flux across the HS membrane,113 which leads to increased Na+K+ATPase activation,114 accelerated ATP breakdown, increased glycolysis, decreased 2,3-diphosphoglycerate, and lower intracellular pH. HS erythrocytes are slightly dehydrated, although the reason for decreased RBC water content is not known. Possibilities include activation of KCC in the acid environment of the splenic cords, or increased Na+K+ATPase activity stimulated in response to increased passive cation leaks, leading to decreased total cation content, water efflux, and cellular dehydration. Dehydration of HS red cells is important because it further impairs their deformability.
Genetics of erythrocyte hydration
Genomewide association studies (GWASs) have demonstrated that a significant component of erythrocyte hydration is genetically determined (reviewed in Kim-Hellmuth and Lappalainen115 ). Variation in indices of erythrocyte hydration, MCHC and MCV, are strongly influenced by genetic factors.116,117 In 1 GWAS, the most significant association for MCHC was a single-nucleotide polymorphism at 16q24 linked to the PIEZO1 gene locus. In another, an enhancer of an erythrocyte calcium ATPase (ATP2B4) was linked to MCHC.118
GWASs have also shown that in most complex diseases, common variants explain only a fraction of genetic risk, as expected from the effects of natural selection. Recent studies indicate rare, independent mutations are major contributors to phenotypic variation in complex diseases, such as hypertension, hypertriglyceridemia, and ischemic stroke. Thus rare, independent mutations may predominate, and analyses of these rare variants add to our understanding of the genetic contributions to complex disease.119 Frequently, these variants identify critical pathways regulating the trait under study, such as rare hypertension-associated mutations in channels, transporters, and regulatory proteins involved in sodium handling by the kidney.120
Thus, coinheritance of disease alleles that influence erythrocyte hydration (eg, HX or SCD), and common or rare alleles that influence erythrocyte hydration and disease, may worsen or ameliorate disease.121,122 Identification of common and rare hydration-associated genetic variants will provide information on the pathways regulating erythrocyte volume homeostasis.
Conclusions
Insights from the clinic and the laboratory are rapidly expanding our knowledge of normal and perturbed erythrocyte hydration. Advances in cell biology, physiology, and, particularly, genetics are contributing to this understanding. Not surprisingly, the genetic bases of disorders of erythrocyte hydration are proving to be heterogeneous, paralleling the variability in clinical, laboratory, and physiologic manifestations observed in patients.
Ongoing work should include rigorous interrogation of genetic variants discovered in the clinic, studies to obtain a detailed understanding of the pathways regulating erythrocyte volume homeostasis. Genomic and proteomic studies are identifying numerous channels, transporters, and regulatory proteins that may contribute to erythrocyte volume control in normal and diseased erythrocytes. Understanding their role in erythrocyte volume homeostasis will likely provide novel insights into control of water and ion content in many cell types. The ultimate goal is translation of this knowledge into therapeutic targets, patient-specific interventions, and other tools to prevent, ameliorate, or cure the consequences of altered erythrocyte hydration in patients with hematologic disease.
Acknowledgments
The author acknowledges the financial support from the Doris Duke Foundation, the American Society of Hematology, and National Institutes of Health, National Institute of Diabetes and Digestive and Kidney Diseases grant DK104046.
Authorship
Contribution: P.G.G. wrote the manuscript.
Conflict-of-interest disclosure: The author declares no competing financial interests.
Correspondence: Patrick G. Gallagher, Department of Pediatrics, Department of Pathology, and Department of Genetics, Yale University School of Medicine, 333 Cedar St, P.O. Box 208064, New Haven, CT 06520-8064; e-mail: patrick.gallagher@yale.edu.

This feature is available to Subscribers Only
Sign In or Create an Account Close Modal